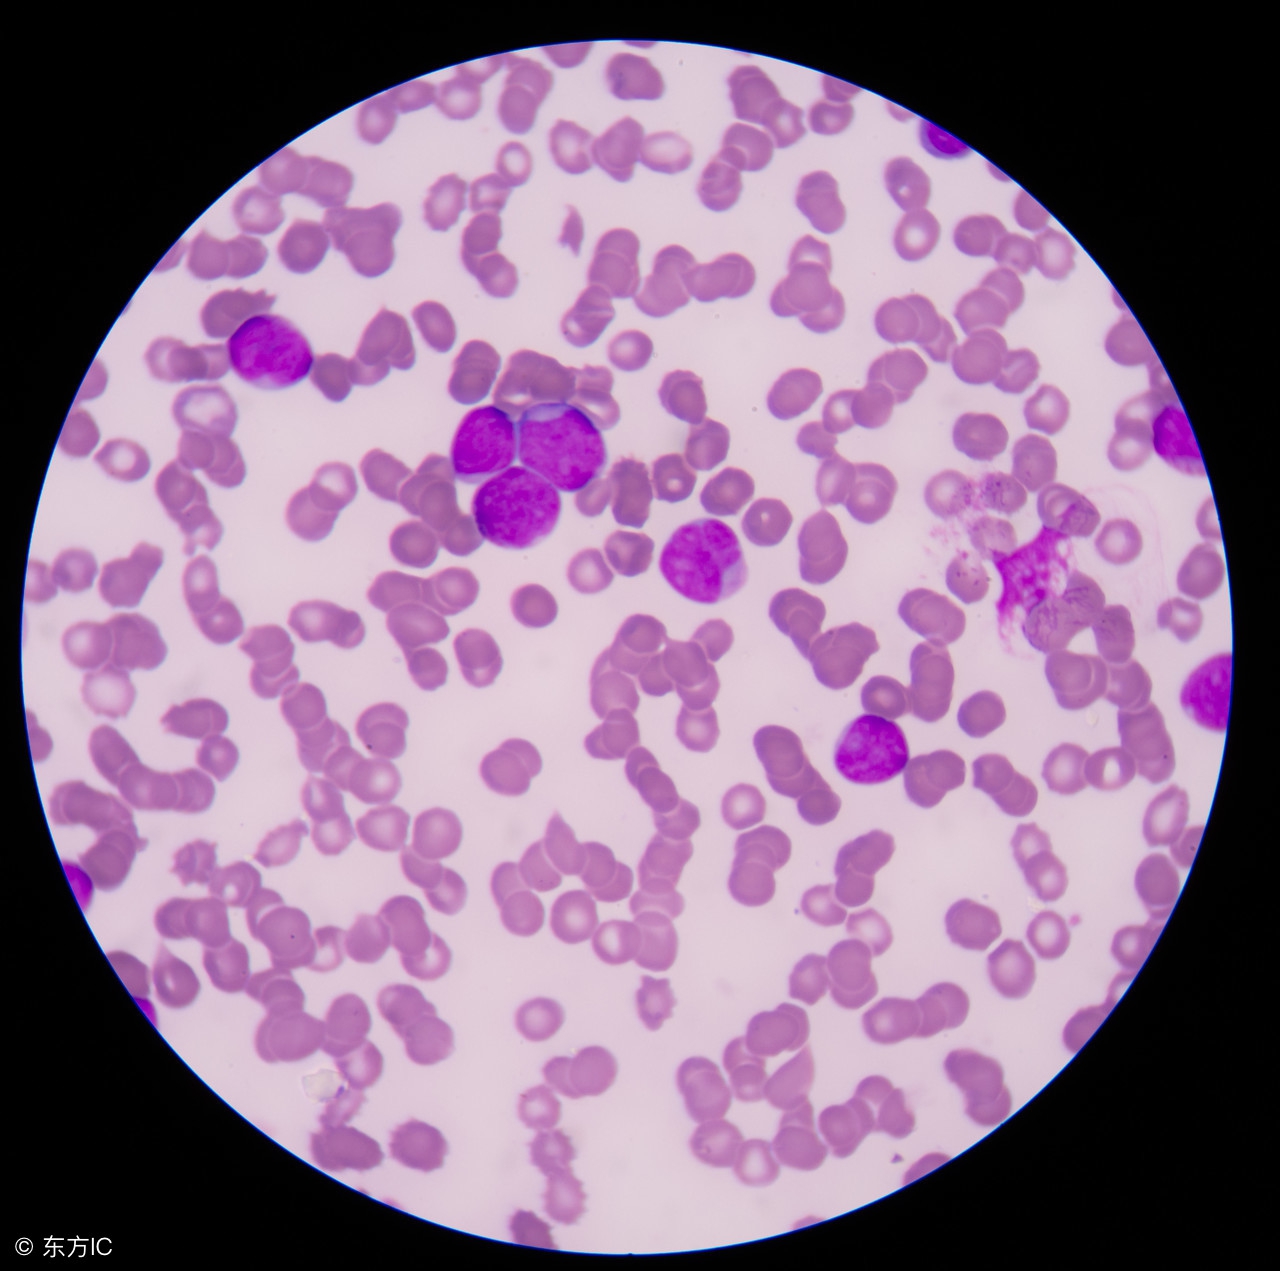
淋巴瘤检查什么最准确,petct检查淋巴瘤

淋巴细胞发生了恶变即称为淋巴瘤,淋巴瘤的病理诊断极其复杂,在没有专门经验的情况下,出错概率比较高。同时,淋巴瘤有几十种不同的分型,一旦误诊,耽误治疗的最佳的时间,下面为你介绍淋巴瘤的诊断方法有哪些?

淋巴瘤基本检查
病史:病人要向医生详细说明得病经过,特别注意有没有发热、消瘦、盗汗等表现。
体验:医生要仔细检查,重点为扁桃体、淋巴结、肝、脾和神经系统。
一般常规检查:血常规、尿常规、大便常规加潜血、胸片(正侧位)、心电图、血型、骨髓涂片等。
血生化:肝功能、肝炎标志物检测、肾功能、电解质系列、血糖、免疫球蛋白等。
影像学检查:腹部B超(包括腹腔淋巴结)。
活检:可取肿大的淋巴结、皮肤包块、肝或脾脏穿刺、骨髓活检等。
淋巴瘤选用检查有哪些
血生化:蛋白电泳、抗人球蛋白试验、腰穿等。
影像学检查:淋巴管造影、磁共振、放射性核素扫描等。
淋巴瘤特殊检查有哪些
血生化:血沉、乳酸脱氢酶、碱性磷酸酶及血钙等。
影像学检查:胸、腹部CT、全胃肠钡餐造影等。
染色体检查:t(14;18)及t(8;14)是最常见的染色体核型异常。
剖腹探查。

淋巴瘤淋巴瘤的诊断标准
霍奇金病
本病的确诊依靠病理组织学检查,没有特征性的临床表现或实验室检查可据此做出诊断。
临床表现:①无痛性淋巴结肿大;②不同部位的淋巴结肿大引起相应的器官压迫症状;③可伴有发热或不伴发热、消瘦、盗汗、皮肤痛痒等全身症状;④随着病情进展,可侵犯腹膜后淋巴结,以及肝、脾、骨、骨髓等结外组织并引起相应症状。
实验室检查:①可有中性粒细胞增多及不同程度的嗜酸性粒细胞增多;②血沉增快及粒细胞碱性磷酸酶活性增高往往反映疾病活跃;③在本病较晚期,骨髓穿刺可能发现典型里德-斯特恩伯格细胞(R-S细胞);④少数病人可并发抗球蛋白试验阳性或阴性深血性贫血。
病理组织学检查:多型性细胞、组织学分四型。
非霍奇金淋巴瘤
临床表现:以无痛性淋巴结肿大为主(约发生于2/3的病人),结外病变可侵犯韦氏咽环、胃肠道、骨、骨髓、皮肤、唾液腺、四状腺、神经系统、*丸睾**等。分别表现为局部肿块、压迫、浸润或出血等症状。20%~30%病人出现发热、体重减轻、盗汗等全身症状。
实验室检查:骨髓受累时,可发生血细胞减少。某些类型非霍奇金淋巴瘤(NHL)易侵犯中枢神经系统,有脑脊液异常。血清乳酸脱氢酶(LDH)水平升高可作为预后不良的指标。
病理组织学检查:系确诊本病的主要依据。其特点为:淋巴结正常结构消失,为肿瘤组织所取代;恶性增生的淋巴细胞形态呈异形性,无里德-斯特恩伯格细胞;淋巴包膜被侵犯。
淋巴瘤的临床分期
本病诊断建立后尚须确定病变范围,进行临床分期,有利于制定合理治疗方案及估计预后。主要用于霍奇金病,非霍奇金淋巴瘤也可参用。
Ⅰ期:病变仅限于一个淋巴结构(Ⅰ),或淋巴结以外单一器官(ⅠE);
Ⅱ期:病变累及横隔同一侧二个或现金的淋巴结区(Ⅱ),或病变局限侵犯淋巴结以外器官及横隔同侧一个以上的淋巴结(ⅡE);
Ⅲ期:膈上下都已有淋巴结病变(Ⅲ),可同时伴有脾累及(ⅢE)或淋巴结以外某一器官受累,加上隔两侧淋巴结受累(ⅢE);
Ⅳ期:病变已侵犯多处淋巴结及淋巴结以外的部位,如累及肺、肝及骨髓等(可表示为骨髓M+、肝H+、骨骼O+、肺L+、胸膜P+、皮肤D+等)。
A组:无全身症状。
B组:有全身症状(连续3天发热达38℃以上,且无明显感染表现;6个月内体重减轻1/10或更多;盗汗,即入睡后就出汗)。
在分期中,"E"表示在淋巴结外的组织或器官病变,且是由邻近的淋巴病病灶直接蔓延的结果。如由纵隔或肺门病灶直接蔓延播散到附近的肺组织局部病变,就和Ⅳ期肺实质性病变在预后和治疗方面有完全不同的意义。